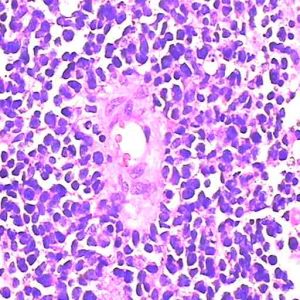
陰道血管肉瘤 陰道血管肉瘤

概述:
性生活有利於發現惡性腫瘤
陰道血管肉瘤在我國的傳統觀念中,很多人認為上了年紀的人就不再需要性生活了。專家認為:性生活有益於更年期婦女的身心健康。
性生活不但能讓女性擁有年輕的心態,增進夫妻感情,在生理上也是對女性陰道的良性刺激,並且容易發現一些惡性腫瘤,例如:陰道血管肉瘤、宮頸癌等等。舉例說,有位女性的陰道血管肉瘤已經長成一顆“肉團”才去就醫,醫生詢問之下得知她的性生活已經停止了很多年。專家指出,在性生活中如果有接觸性出血,便可能是微小的癌變病灶,如果這位女性平時有性生活,便不至於癌變發展到一顆肉團那么大才被發現。
陰道血管肉瘤是由什麼原因引起的?
(一)發病原因
1.病毒感染Gessi等(2002)採用PCR原位雜交以及電鏡下直接觀察病毒體發現陰道血管肉瘤中有人類單純皰疹病毒-8(HHV-8)存在認為HHV-8的感染與血管肉瘤的發生有關
陰道血管肉瘤2.慢性刺激2例陰道上皮樣血管肉瘤患者均有數年陰道放置子宮托史
3.放療共有4例患者分別因為子宮內膜癌宮頸腺癌宮頸鱗癌宮頸鱗癌接受盆腔放療9142021年後在放療部位出現血管肉瘤Morimura等(2001)認為要診斷放療引起的血管肉瘤需除外慢性淋巴水腫而且必須數年後發生在原來放療部位
(二)發病機制
腫瘤呈血皰樣或境界不清的斑塊切面呈紫紅色微囊狀或海綿狀邊界不清而鏡下所見浸潤的範圍遠超過肉眼所見者
鏡檢見明顯擴張的血管瘤樣腔道大小形態不規則相互吻合形成錯綜複雜的竇隙狀網腔隙內可見紅細胞瘤細胞在基底膜內增生可貼附於血管內壁形成結節狀突出於管腔瘤細胞多呈梭形未分化者呈多邊形類內皮細胞樣或呈上皮樣核異型性明顯核分裂象多見電鏡下可見內皮分化如部分覆蓋基底膜細胞間緊密連線及吞飲小泡偶見微絲Weibel-Palade小體小管結構等
免疫組化血管內皮標誌物FⅧ因子CD31CD34大部分為陽性上皮樣血管肉瘤部分低分子角蛋白也可呈陽性
陰道血管肉瘤有哪些表現及如何診斷?
陰道血管肉瘤主要表現為陰道出血可伴排尿困難腫塊位於陰道殘端陰道上壁和陰道穹隆等為不規則硬結大小2~8cm不等表面可有潰瘍亦可浸潤陰道壁
陰道血管肉瘤可根據臨床表現症狀和實驗室相關檢查做出診斷確診主要依靠病理組織學檢查
陰道血管肉瘤應該做哪些檢查?
腫瘤標誌物檢查分泌物檢查組織病理學檢查
陰道血管肉瘤容易與哪些疾病混淆?
上皮樣血管肉瘤需注意與上皮樣肉瘤轉移性癌相鑑別除鏡下可見少量血管瘤樣圖像外上皮樣血管肉瘤內皮標誌物陽性
陰道血管肉瘤可以並發哪些疾病?
潰瘍破潰感染
陰道血管肉瘤應該如何預防?
早期發現早期治療做好隨訪
陰道血管肉瘤應該如何治療?
6例患者予手術加放療2例行根治性手術1例在術後3月死於多器官功能衰竭另1例在盆腔除髒術後並發出血而死亡3例無法手術予化療或放療除Morimura等報導的1例在環磷醯胺長春新鹼多柔比星(阿黴素)和達卡巴嗪(氮烯咪胺)化療加阿地白介素(白細胞介素-2)治療後完全緩解隨訪15個月無瘤生存外其餘2例效果差
症狀體徵
可發生於任何年齡成人多見少數為先天性好發於皮膚皮下肌肉和骨組織,也可發生於口腔縱隔和腹膜後等部位常見於四肢特別是下肢其次為軀幹頭頸部,通常是單發大小不一直徑為1~4cm質硬呈結節狀或斑塊,表麵皮膚正常偶見靜脈曲張或毛細血管擴張有時表現為良性邊界清楚生長緩慢,而惡性者生長快呈侵襲性生長還有一些則形成轉移肺,最易受累有些病例在皮膚腫瘤切除後數年還能發生轉移其途徑可能通過淋巴管或血流。
血管肉瘤占脈管腫瘤的1%~2%。深部組織的血管肉瘤極為罕見,所占比例不足全部肉瘤的1%,各年齡組均可發病,男女發病率相近。好發部位為頭面部皮膚、乳房、大腿深部肌肉,其次為腹膜後、軀幹及四肢皮膚。本瘤惡性程度較高,常在早期即可經血循環轉移至肝、肺、骨,經淋巴可轉移至引流區淋巴結。易導致慢性淋巴水腫。
臨床上血管肉瘤大多表現為漸進性增大的軟組織腫塊,生長較快,易並發出血。1/3的患者同時伴有其他症狀,如凝血異常、貧血、持續性血腫和瘀斑。年齡非常小的患者可因動靜脈分流甚至大量出血引起高排血量性心衰。
預後
陰道血管肉瘤預後差平均生存期為14個月4例患者在10個月內死亡其中2例上皮樣血管肉瘤分別在3個月4個月死亡2例分別隨訪3年15個月無瘤生存其餘均在51個月內死亡
醫學疾病任務——婦科
| 婦科是醫療機構的一個診療科目,是婦產科的一個分支專業,是以診療女性婦科病為診療的專業科室。女性生殖系統所患的疾病才叫婦科疾病。婦科疾病的種類可分很多種,本任務包含大多數婦科疾病。 |